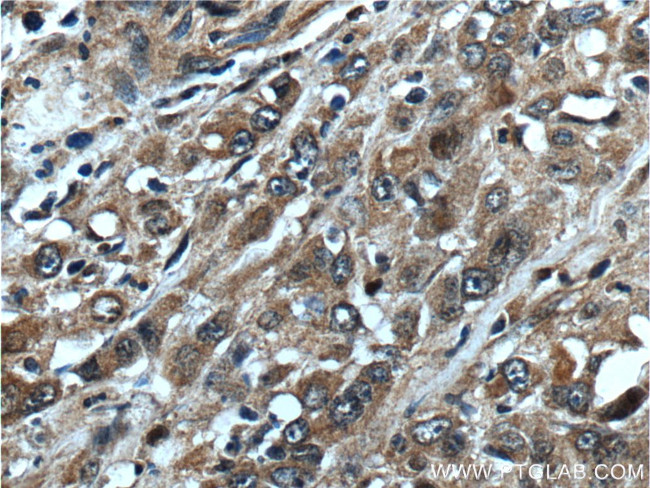
NANS Antibody in Immunohistochemistry (Paraffin) (IHC (P))

Search
Proteintech
NANS Polyclonal Antibody
{{$productOrderCtrl.translations['antibody.pdp.commerceCard.promotion.promotions']}}
{{$productOrderCtrl.translations['antibody.pdp.commerceCard.promotion.viewpromo']}}
{{$productOrderCtrl.translations['antibody.pdp.commerceCard.promotion.promocode']}}: {{promo.promoCode}} {{promo.promoTitle}} {{promo.promoDescription}}. {{$productOrderCtrl.translations['antibody.pdp.commerceCard.promotion.learnmore']}}
产品信息
15163-1-AP
种属反应
宿主/亚型
分类
类型
抗原
偶联物
形式
浓度
规格
纯化类型
保存液
内含物
保存条件
运输条件
产品详细信息
Immunogen sequence: MPLELELCP GRWVGGQHPC FIIAEIGQNH QGDLDVAKRM IRMAKECGAD CAKFQKSELE FKFNRKALER PYTSKHSWGK TYGEHKRHLE FSHDQYRELQ RYAEEVGIFF TASGMDEMAV EFLHELNVPF FKVGSGDTNN FPYLEKTAKK GRPMVISSGM QSMDTMKQVY QIVKPLNPNF CFLQCTSAYP LQPEDVNLRV ISEYQKLFPD IPIGYSGHET GIAISVAAVA LGAKVLERHI TLDKTWKGSD HSASLEPGEL AELVRSVRLV ERALGSPTKQ LLPCEMACNE KLGKSVVAKV KIPEGTILTM DMLTVKVGEP KGYPPEDIFN LVGKKVLVTV EEDDTIMEEL VDNHGKKIKS (1-359 aa encoded by BC000008)
靶标信息
This gene encodes an enzyme that functions in the biosynthetic pathways of sialic acids. In vitro, the encoded protein uses N-acetylmannosamine 6-phosphate and mannose 6-phosphate as substrates to generate phosphorylated forms of N-acetylneuraminic acid (Neu5Ac) and 2-keto-3-deoxy-D-glycero-D-galacto-nononic acid (KDN), respectively; however, it exhibits much higher activity toward the Neu5Ac phosphate product. In insect cells, expression of this gene results in Neu5Ac and KDN production. This gene is related to the E. coli sialic acid synthase gene neuB, and it can partially restore sialic acid synthase activity in an E. coli neuB-negative mutant.
仅用于科研。不用于诊断过程。未经明确授权不得转售。
篇参考文献 (0)
生物信息学
蛋白别名: 3-deoxy-D-glycero-D-galacto-nononate 9-phosphate synthase; epididymis secretory protein Li 100; N-acetylneuraminate-9-phosphate synthase; N-acetylneuraminic acid 9-phosphate synthetase; N-acetylneuraminic acid phosphate synthase; N-acetylneuraminic acid synthase; NANS; RP11-404F11.3; Sialic acid phosphate synthase; Sialic acid synthase; unnamed protein product
基因别名: 4632418E04Rik; BB056474; HEL-S-100; NANS; SAS; SEMDCG; SEMDG
UniProt ID: (Human) Q9NR45, (Mouse) Q99J77
Entrez Gene ID: (Human) 54187, (Mouse) 94181, (Rat) 298071